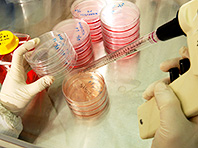
Ученые создали уникальные имплантаты для пересадки костного мозга

JAMA: стероиды позволяют проводить имуннотерапию рака после пересадки органов
Ученые из Университета Флиндерса (Австралия) выяснили, что добавление ингибиторов mTOR и стероидов к стандартной иммунотерапии позволяет безопасно лечить рак у пациентов с пересаженными органами. «До сих пор таким пациентам часто отказывали в терапии из-за высокого риска отторжения трансплантата — иммунотерапия активирует защитные силы организма, которые могут атаковать не только опухоль, но и донорский орган. Однако…